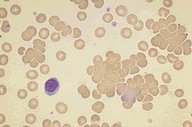

Description
This high dry magnification photomicrograph is from a patient with
cold agglutinin disease. The characteristic agglutinated or clumped
red cells are clearly apparent in this field.
|
|
Click on this image
to enlarge it, then
on Back buttom
in the Netscape Menu
to shrink it back down



|